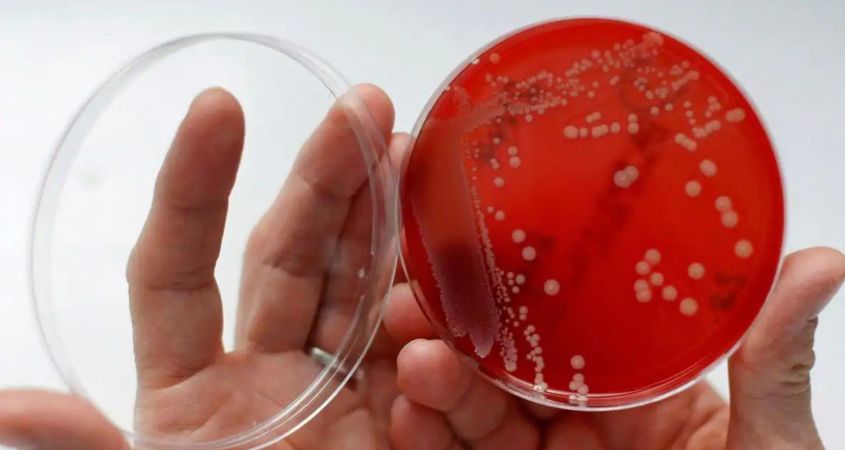

En Japón, la preocupación ha aumentado debido al récord de casos de síndrome de shock tóxico estreptocócico (STSS), una infección bacteriana potencialmente mortal conocida como la «enfermedad carnívora».
Este síndrome, causado por bacterias estreptococos del grupo A, puede provocar necrosis en los tejidos conectivos que cubren los músculos y ha mostrado un aumento significativo en comparación con años anteriores.
¿Qué tan grave son los casos de bacteria carnívora en Japón?
Según un informe del Instituto Nacional de Enfermedades Infecciosas de Japón, en 2023 se diagnosticaron 941 casos de STSS, superando el récord anterior de 894 establecido en 2019.
Esta cifra ha llevado a las autoridades a temer que 2024 sea el año con mayor número de casos registrados en Japón. El STSS puede ser especialmente peligroso en adultos mayores de 30 años, y se han reportado varias muertes en cuestión de horas por fallos orgánicos múltiples.
¿Cómo se transmite la bacteria carnívora?
La infección por estreptococo A, que causa el STSS, se transmite principalmente a través de pequeñas gotas de saliva y puede provocar una variedad de síntomas, como dolor de garganta, fiebre, diarrea, vómitos o fatiga intensa. En casos graves, la infección puede causar insuficiencia renal, dificultad respiratoria aguda o coagulación intravascular diseminada, una anomalía de la coagulación que puede provocar hemorragias y trombosis.
Los expertos han destacado que el aumento de casos podría estar relacionado con el levantamiento de las restricciones por la pandemia de Covid-19, que habrían ayudado a contener esta otra infección.
Las autoridades sanitarias han instado a la población a tomar medidas preventivas básicas, como lavarse las manos y limpiarse bien las heridas, para evitar la propagación de la bacteria.
A pesar de la gravedad de la situación en Japón, el STSS sigue siendo considerado una enfermedad rara. Sin embargo, el aumento de casos ha generado preocupación y atención tanto a nivel nacional como internacional, con la esperanza de encontrar la causa exacta de este aumento y tomar medidas para contener la propagación de la enfermedad.
Información. Periódico Correo.